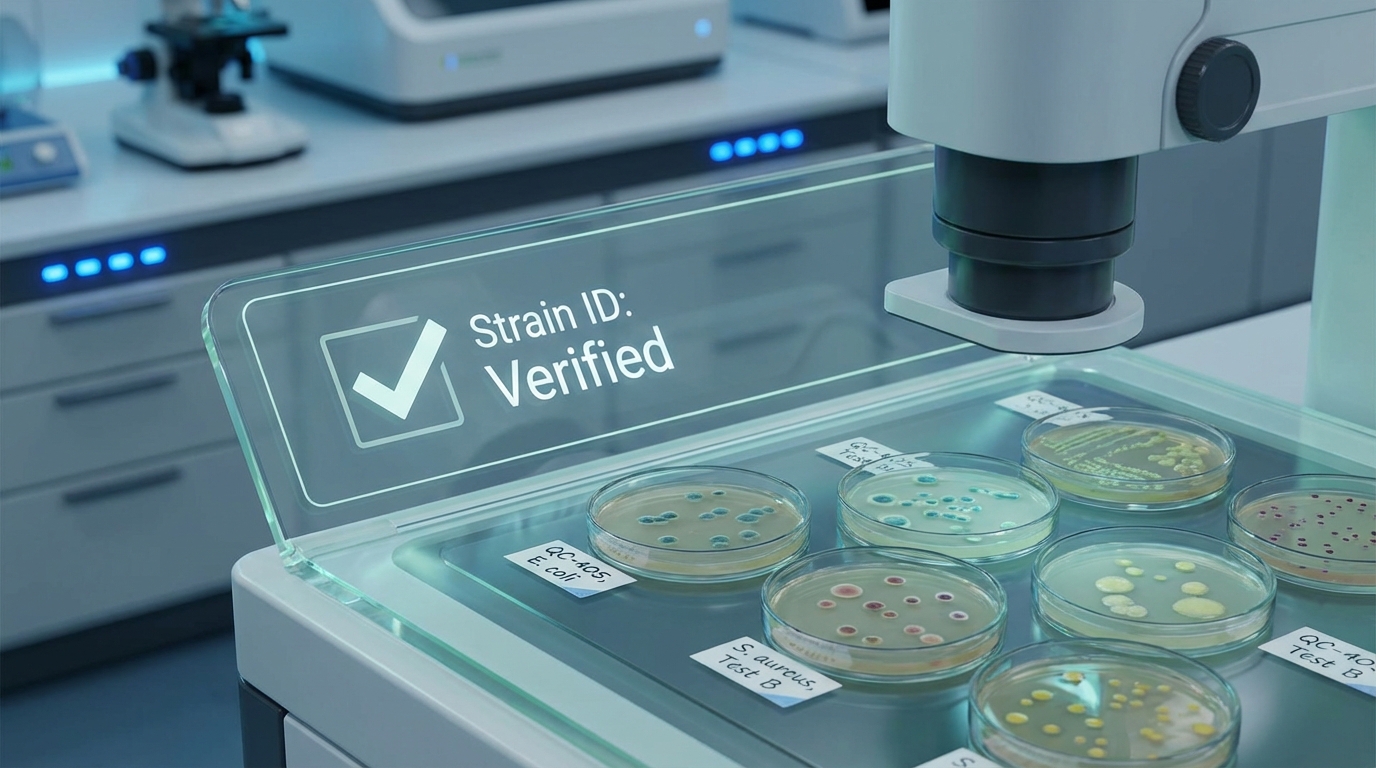
유산균 품질 검증 및 균주 식별 과정

1. 유산균(Probiotics)의 생화학적 기전 및 흡수율 분석

유산균, 즉 프로바이오틱스는 단순히 ‘장 건강’을 넘어 신체 전반의 항상성을 유지하는 생체 활성 미생물입니다. 이들의 핵심 기전은 장내 상피 세포에 부착하여 유해균의 증식을 억제하는 ‘경쟁적 배제’와 단쇄지방산(SCFA, Short-Chain Fatty Acids)의 생성에 있습니다.
1.1 장내 세균총의 면역 조절 메커니즘
유산균은 장관 면역계(GALT)를 자극하여 면역글로불린 A(IgA) 생산을 촉진하고, 조절 T세포(Treg)의 활성을 유도하여 과도한 염증 반응을 억제합니다. 이는 장 건강뿐만 아니라 아토피, 비염 등 면역 질환 개선에 기여하는 생화학적 근거가 됩니다.
1.2 생존율과 도달율의 함수 관계
유산균의 ‘흡수율’은 엄밀히 말해 ‘장내 정착률’을 의미합니다. 위산(pH 1.5~2)과 담즙산의 파상공세를 뚫고 대장까지 살아 도달하는 비율이 핵심이며, 최근에는 이를 극대화하기 위해 장용성 캡슐 공법이나 다중 코팅 기술이 적용되고 있습니다.
2. 치명적 부작용 및 드럭 머거(Drug Mugger) 주의사항

모든 이에게 유산균이 안전한 것은 아닙니다. 특히 면역력이 극도로 저하된 환자나 기저 질환이 있는 경우, 생균 섭취는 오히려 독이 될 수 있습니다.
⚠️ 약사의 경고: 항암 치료 중이거나 면역억제제를 복용 중인 환자가 고함량 유산균을 섭취할 경우, 균이 혈류로 유입되어 패혈증(Sepsis)이나 균혈증을 유발할 위험이 있습니다. 또한 장내 세균 과증식(SIBO) 환자는 증상이 악화될 수 있으므로 반드시 전문가와 상의하십시오.
2.1 대표적인 드럭 머거: 항생제
항생제는 유해균뿐만 아니라 유익균까지 무차별적으로 사멸시키는 대표적인 드럭 머거(Drug Mugger)입니다. 항생제 복용 시 유산균을 함께 섭취하면 항생제 유발 설사(AAD)를 예방할 수 있으나, 약물 효능 간섭을 피하기 위해 최소 2시간 이상의 시간 간격을 두어야 합니다.
3. 약사가 알려주는 고품질 제품 선별 기준
단순히 ‘CFU(보장균수)’가 높다고 좋은 유산균이 아닙니다. 임상 약학적 관점에서 품질을 결정하는 요소는 따로 있습니다.
3.1 균주 이름(Strain Code) 확인의 중요성
라벨에 단순히 ‘Lactobacillus acidophilus’라고만 적힌 제품보다는 뒤에 ‘DDS-1’이나 ‘LGG’ 같은 고유 식별 코드가 붙은 제품을 선택하십시오. 이 코드가 있어야 해당 균주의 기능성과 안전성에 대한 임상 데이터가 존재함을 보증합니다.
3.2 투입균수 vs 보장균수
제조 시 넣는 ‘투입균수’는 마케팅 용어에 불과합니다. 소비자에게 중요한 것은 유통기한 끝까지 살아남는 것을 보장하는 ‘보장균수(Guaranteed CFU)’입니다. 식약처 기준 1일 권장 섭취량인 1억~100억 CFU 범위를 충족하는지 반드시 확인하십시오.
4. 시너지를 위한 최적의 복용 시간 및 조합

유산균의 효과를 극대화하려면 ‘언제’, ‘무엇과’ 먹느냐가 핵심입니다.
4.1 골든 타임: 기상 직후 공복
일반적으로 유산균은 위산의 농도가 가장 낮은 기상 직후 공복 상태에 미지근한 물 한 잔과 함께 복용하는 것이 가장 권장됩니다. 물은 위산을 희석하여 유산균이 위를 빠르게 통과하게 돕습니다.
4.2 시너지 조합: 프리바이오틱스와의 만남
유산균(프로)의 먹이가 되는 식이섬유나 프락토올리고당(프리바이오틱스)을 함께 섭취하면 장내 정착률이 비약적으로 상승합니다. 이를 ‘신바이오틱스(Synbiotics)’라고 하며, 최근에는 포스트바이오틱스(대사산물)까지 포함된 4세대 제품군이 주목받고 있습니다.
글 요약: 유산균은 장내 면역 조절과 SCFA 생성을 통해 전신 건강에 기여합니다. 하지만 면역 저하자는 패혈증 위험이 있으므로 주의해야 하며, 항생제와는 2시간 간격을 두어야 합니다. 제품 선택 시에는 ‘보장균수’와 ‘균주 코드’를 반드시 확인하고, 기상 직후 공복에 프리바이오틱스와 함께 섭취하는 것이 가장 효과적입니다.





